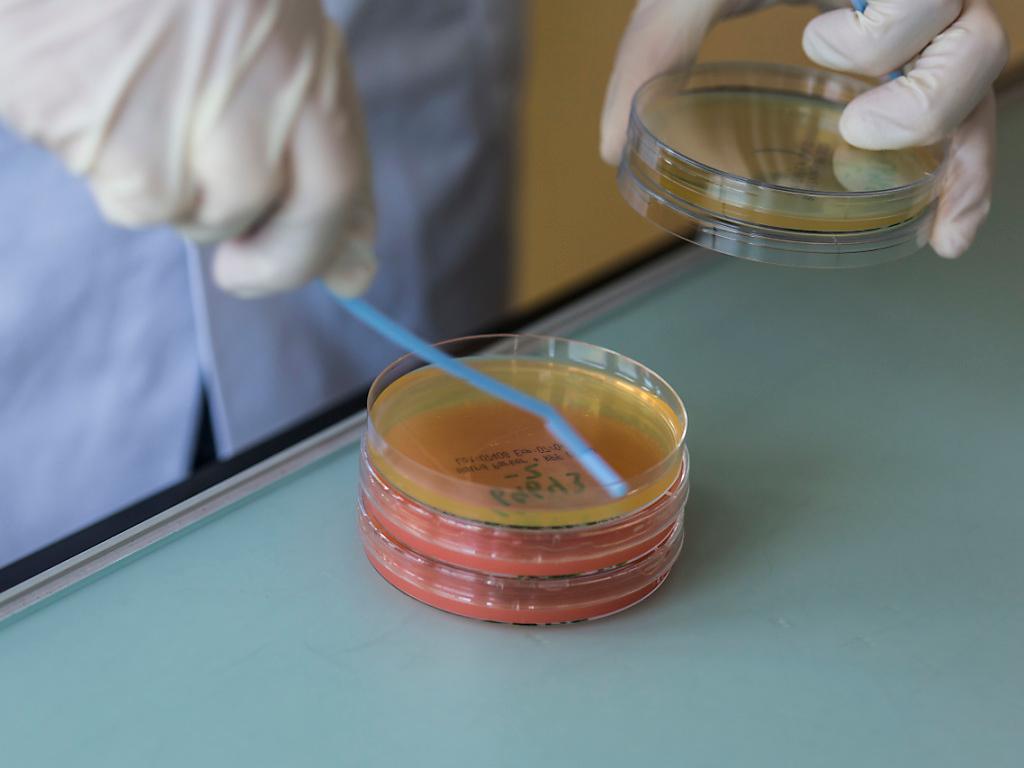

Des listérias dans des morceaux de noix de coco
(Keystone-ATS) Des listérias ont été décelées dans des morceaux de noix de coco frais du producteur Sylvain & Co, vendus exclusivement par Manor. Un danger pour la santé n’étant pas exclu, l’Office fédéral de la sécurité alimentaire (OSAV) recommande de ne pas consommer le produit.
Le grand distributeur a immédiatement ordonné le retrait des rayons et le rappel du produit dans les filiales concernées, précise l’OSAV samedi dans un communiqué.
Chez les personnes avec un système immunitaire sain, une infection aux listérias ne provoque le plus souvent que des symptômes légers, voire aucun symptôme. Les personnes immunodéprimées peuvent quant à elles manifester toute une série de symptômes graves, dont l’issue peut être fatale.
Pendant la grossesse, une infection aux listérias peut entraîner une fausse couche ou bien provoquer une septicémie ou une méningite chez l’enfant à sa naissance, rappelle l’OSAV.














![Le tableau "Sonntag der Bergbauern" [Dimanche des paysans de montagne, 1923-24/26], d'une longueur de quatre mètres, a dû être transporté par une grue depuis la Chancellerie allemande à Berlin pour être exposé à Berne.](https://www.swissinfo.ch/content/wp-content/uploads/sites/13/2025/12/01_Pressebild_KirchnerxKirchner.jpg?ver=6bad6e1f)










